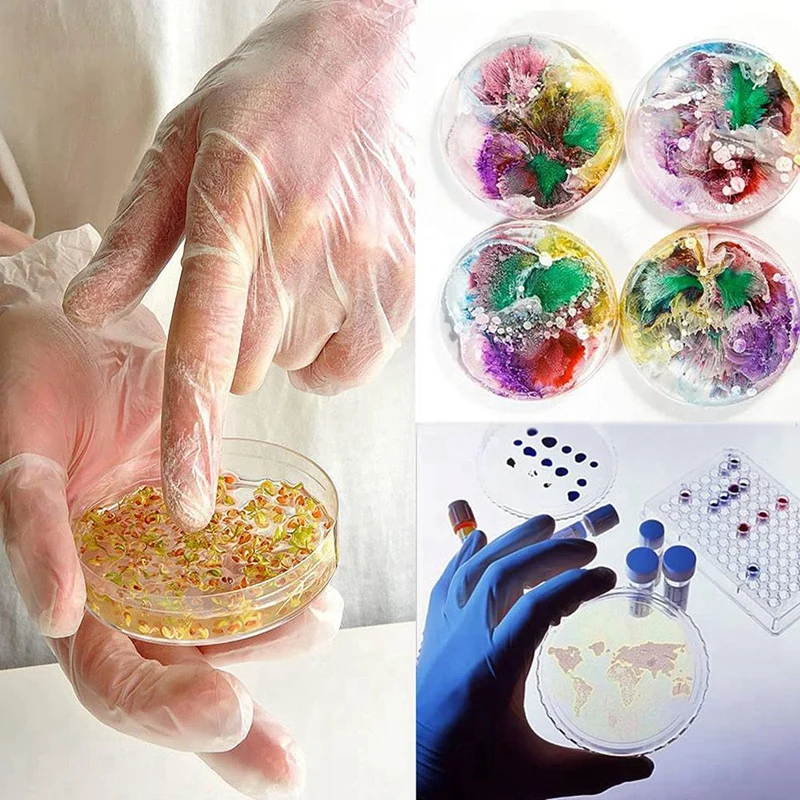
thumb

Стерильные пластиковые чаши Петри с крышкой, прозрачные чаши Петри с пипетками для лаборатории, экспериментальный урок, Клеточная культура

артикул: 1005004716485630
СОГЛАСНО НАШИМ ДАННЫМ, ЭТОТ ПРОДУКТ СЕЙЧАС НЕ ДОСТУПЕН
$11.84
Доставка из: Китай
График изменения цены & курс обмена валют
Пользователи также просматривали

$45.91
Зимние мотоциклетные защитные ботинки, водонепроницаемые Нескользящие зимние ботинки, женские кожаные утепленные теплые ботинки с коротким рукавом и плюшем
aliexpress.ru
$3.23
1 ~ 7 шт. Бумага для термопринтера, цветной мини-рулон печатной бумаги и самоклеящаяся бумажная бумага для фотографий A6 Poooli paperang
aliexpress.ru
$3.53
Рюкзак с деревом жизни под заказ, сумка на шнурке для покупок, рюкзак для йоги, Женский Мужской спортивный рюкзак Vikings для спортзала
aliexpress.ru
$15.50
Рождественское украшение, светодиодная лампа в виде звезды, романтическая Европейская лампа, искусственная нить для комнаты, дома, свадьбы, Хэллоуина, украшение для окон
aliexpress.ru
$17.84
Useful Night 425 Battery Float Bite Alarm Fluorescent Light Glow Stick Fishing Rod Tip Lightstick Green
joom.ru
$141.92
Мужские спортивные тканые шорты с цветными блоками и мультяшным узором Nike, черные DM7919-014 L
joom.ru
$9.99
Floleo Tops Clearance Maternity V-Neck Long Sleeve Bandage Solid Color Breast-Feeding Pregnant Nursing Blouse Tops
walmart.com
$17.22
Облегающее платье с абстрактными буквами, женское элегантное Макси-Платье с рисунком, праздничное уличное модное платье с коротким рукавом...
aliexpress.ru
$0.15
30pc color mini cotton thread tassel boho jewelry making supplies bracelet necklace finding fringe trim pendants small tassels h jllcud
dhgate.com
$25.72
new music box with screws music box party decoration play set 6 tones movement diy mechanical metal music boxes clockwork
dhgate.com
$32.94
housing shell case cover+screen lens protector +stick label for gameboy advance gba console
dhgate.com









